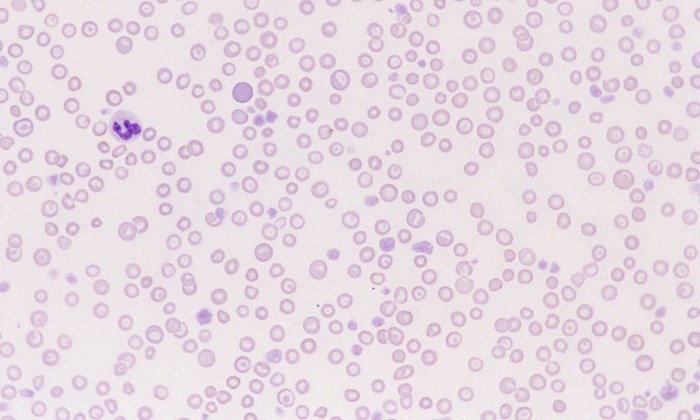
Hypochromasia 4 (Canine 4 - Iron Deficiency)
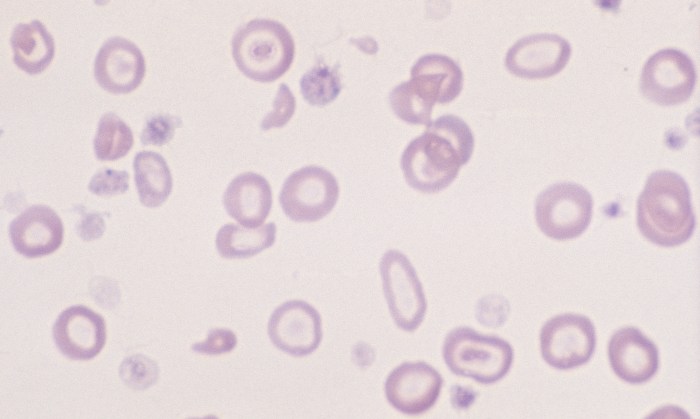
Hypochromasia 2 (Canine 2 - Iron Deficiency)
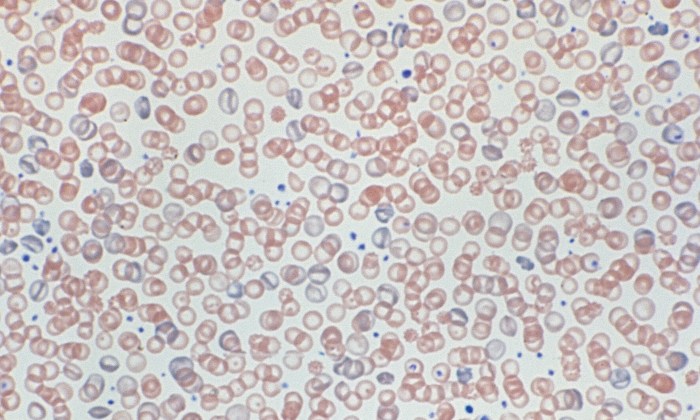
Hypochromasia 6 (Canine 6)

Hypochromasia
Morphology: red blood cells that stain pain with increased central pallor and thin rim of hemoglobin (decreased hemoglobin content).
Look alike: torocytes (increased central pallor with normal thick rim of hemoglobin).
Commonly seen with: other features of iron deficiency (anemia, microcytes).
Clinical relevance: usually associated with advanced iron deficiency. May also be observed with other deficiencies (copper, vitamin B6) or toxicities (chronic lead poisoning). Hypochromasia can be associated with decreased mean corpuscular hemoglobin concentration (MCHC) on CBC.